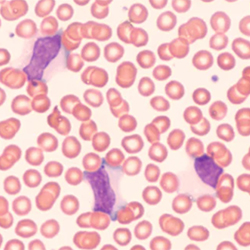

By IDSE News Staff
The FDA issued a complete response letter (CRL) to Atara Biotherapeutics for tabelecleucel (Ebvallo) as monotherapy treatment for adults and children 24 months of age and older with Epstein-Barr virus–positive post-transplant lymphoproliferative disease (EBV+PTLD), who have received at least one prior therapy including an anti-CD20–containing regimen.

The CRL was related to observations as part of a standard prelicense inspection of a third-party manufacturing facility for tabelecleucel and did not identify any deficiencies related to the manufacturing process, the clinical efficacy or clinical safety data in the Biologics License Application (BLA). In addition, the FDA did not request any new clinical trials to support the approval of tabelecleucel.
“We are working closely with our partner Pierre Fabre Laboratories, the FDA and the third-party manufacturer to address the feedback to support marketing approval for Ebvallo,” said Cokey Nguyen, PhD, the president and CEO of Atara. “Once the third-party manufacturer GMP [Good Manufacturing Practice] compliance issues have been adequately addressed, we will file for a resubmission, which we would expect to be potentially approved within six months of resubmission. Atara and its partner Pierre Fabre remain confident in the potential of Ebvallo and are committed to bringing this potential first-in-class medicine to U.S. patients with EBV+PTLD who have limited treatment options and significant unmet need.”
Tabelecleucel, which was granted marketing authorization by the European Commission in December 2022, is an allogeneic, EBV-specific T-cell immunotherapy designed to target and eliminate EBV-infected cells. The BLA in the United States is based on results from the pivotal ALLELE study demonstrating a statistically significant 50% objective response rate and favorable safety profile.